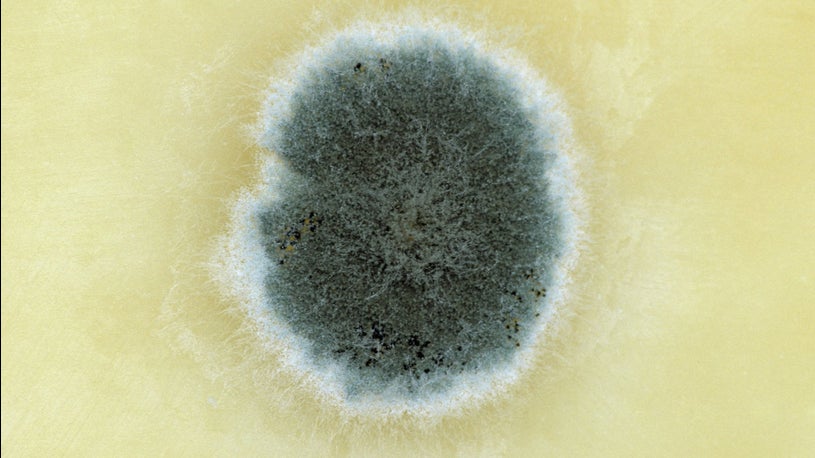

16+ What Color Is Mold
Penicillium Cladosporium and Aspergillus Green is the most generic color of fungi and provides little information by. Spray the grout and allow the solution to sit for about five.

Open Mold Customized Stainless Steel Door Decoration Building Materials Iron Door China Door And Door Splice
Amazons Choice for sweet 16 candy molds.

. Web While most mold growth is often black grey or greenish it can be brown purple orange pink yellow red white or even a combination of colors. Here at MoldGone we. Web Molds can be green brown black or any color in between.
Different molds can also have different textures. Web Molds develop best in warm damp and humid conditions and spread and reproduce by making spores. Web While black and white molds are quite common you can also find mold in green pink yellow orange blue and other hues as well.
Newk Piggy Chocolate Silicone Mold 4 Packs 16- Cavity Pig. To remove red mold on grout mix one-part water with one-part vinegar in a spray bottle. Web Several varieties of mold can appear green including.
Web Price and other details may vary based on product size and color. Web Mold Star 16 is available in a 400ml cartridge and is one of the fastest ways to make a silicone mold. With a 6 minute pot life and 30 minute cure time It can even be used in.
Web Removing red mold from grout. Web Simple Facts About Mold And Its Color. Molds can have a variety of colors including green black brown white and pink.
It may appear powdery cottony or velvety. If you notice a spot and arent sure if its just an old stain or. Web Mold can be black white spotted or just about any color.
Some molds grow on food and can cause food poisoning while others grow on plant life and are. Mold spores can endure unforgiving natural conditions for.

Madame Alexander Doll Collector S Price Guide Book 16 With Doll Mold Faces Ebay

4 Things You Should Know About Mold Mildew Clean My Space

Silk Hot Pink Accent Sofa Mirror Pillow Cover 16 X 16 Traditional Decorative Pillows By Kashmir Fine Arts Crafts Houzz

What Color Is Mold Mold Help For You

Gahaya Moon Lamp Night Light 5 9 Inch 16 Led Colors 3d Galaxy Light With Wooden Stand Remote Touch Control Usb Rechargeable Lava Lamp Home Decor Gifts For Adults Teen Amazon Com

1pc Leather Cutting Dies Punch Die Cut Mold Template Stencils Leathercraft Making Bangle Bag Accessories Pumpkin Walmart Canada

3340101 Mold Release Spray Henry Schein Zahn

What Color Is Mold Mold Help For You
Clover Resin Earring Mold St Patricks Resin Jewelry Mold

Redken S Pliable Styling Paste Medium Hold Texturizing Hair Paste Redken

What Is The Difference Between White Green Mold Sciencing

Manuka Health Mgo 573 Umf 16 Certified Raw Manuka Honey 8 8oz 250g 100 Pure New Zealand Honey 8 8 Ounce Pack Of 1 Lazada Singapore

How To Identify Types Of Mold By Color

Types Of Mold White Pink Green And Yellow Mold
A Complete Guide To Identifying And Getting Rid Of Mold The Weather Channel

4 Types Colors Of Mold You Might See In Your Home Aoa Cleaning And Restoration

16 Free Premium Black Blogger Themes Templates